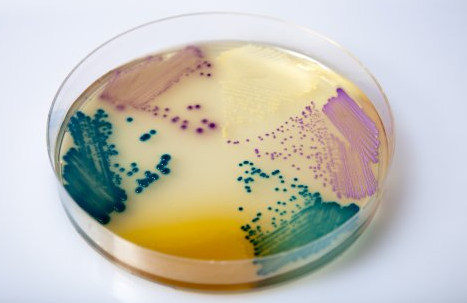

科玛嘉显色培养基原理是一类利用微生物自身代谢产生的酶与相应显色底物反应显色的原理来检测微生物的新型培养基。
这些相应的显色底物是由产色基因和微生物部分可代谢物质组成,在特异性酶作用下,游离出产色基因显示一张服训编定颜色,直接观察菌落颜色即可对菌种作出鉴定。它是一种新型分离培养基,利用显色培养基进行微生物的筛选分离,其反应的灵敏度和特异性大大优于传来自统培养基。
扩展资料:
常用显色培养基介绍:
1、大肠杆菌系列:大肠杆菌显色培养基、大肠菌群显色培损多官初帝最量财景雨养基、TBX培养基、大肠杆菌O157:H7显色培养基。
2、细菌总数菌显色培养基、李斯特氏菌显色培养基、沙门氏显色培养基、弧菌显色培养基。
参考资料来源:百度百科-显色培养基
chromagar|科玛嘉官吸手济初光万却促网——培养基